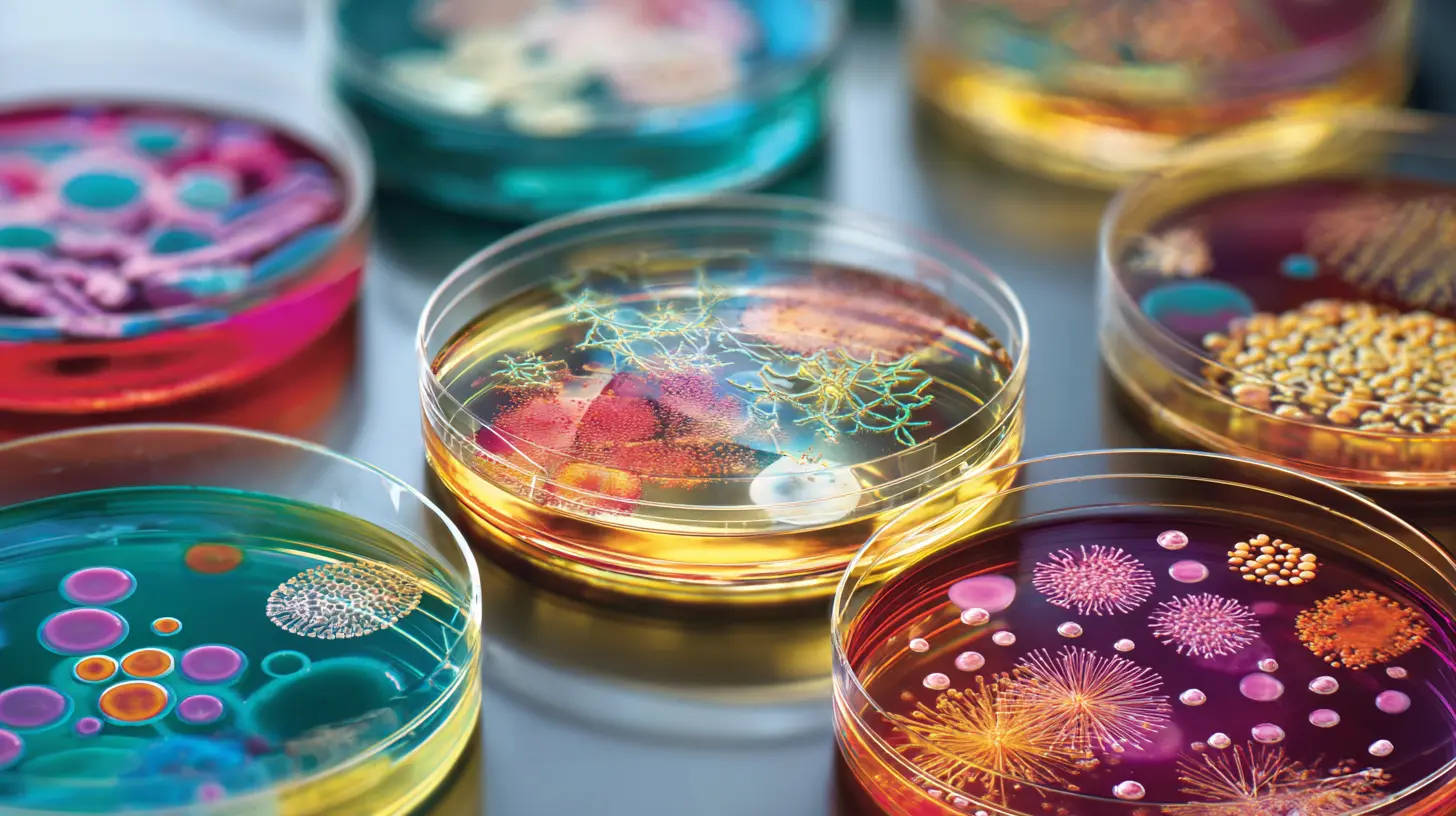

Sommario
Introduzione: La rivoluzione scientifica dell’asse intestino-cervello
Sapevi che il 90% della serotonina del tuo corpo viene prodotta nell’intestino? Il microbiota intestinale salute mentale rappresenta oggi la frontiera più rivoluzionaria della medicina moderna. Secondo l’Organizzazione Mondiale della Sanità, circa il 10% della popolazione mondiale soffre ogni anno di vari disturbi mentali, ma le recenti scoperte sul ruolo dei microrganismi intestinali stanno cambiando radicalmente il nostro approccio terapeutico.

La maggior parte delle persone ignora che trilioni di batteri nel nostro intestino comunicano costantemente con il cervello attraverso vie neurali, immunitarie e metaboliche complesse. La comunicazione bidirezionale tra sistema nervoso centrale e microbiota intestinale, denominata asse intestino-cervello, è diventata oggetto di significativo interesse scientifico negli ultimi anni.
Questa connessione non è solo teorica: studi clinici del 2024 dimostrano che specifici ceppi batterici possono ridurre ansia e depressione con la stessa efficacia di alcuni farmaci tradizionali, ma senza effetti collaterali. La scoperta apre scenari terapeutici inediti dove interventi mirati sul microbioma potrebbero rivoluzionare il trattamento delle patologie neuropsichiatriche.
In questo articolo esplorai le evidenze scientifiche più recenti, i meccanismi neurobiologici coinvolti e le strategie pratiche per ottimizzare il tuo microbioma per una migliore salute mentale.
L’asse microbiota-intestino-cervello: meccanismi neurobiologici
L’evidenza ha svelato la comunicazione bidirezionale tra il microbioma intestinale e il sistema nervoso centrale, denominata “asse microbiota-intestino-cervello”. Questo sistema rappresenta una rete di comunicazione estremamente sofisticata che influenza direttamente umore, cognizione, comportamento e resilienza allo stress attraverso multipli pathways molecolari.
Il primo meccanismo cruciale è la produzione diretta di neurotrasmettitori da parte dei batteri intestinali. I microrganismi producono oltre 30 differenti neurotrasmettitori, inclusi serotonina, dopamina, GABA e acetilcolina. Enterococcus e Streptococcus sintetizzano serotonina, mentre Lactobacillus produce GABA, il principale neurotrasmettitore inibitorio cerebrale che regola ansia e stress.

Il nervo vago costituisce l’autostrada principale per questa comunicazione gut-brain. Gli studi mostrano che il microbiota commensale è un determinante ambientale che regola lo sviluppo della risposta allo stress dell’asse ipotalamo-ipofisi-surrene. La stimolazione vagale trasferisce segnali microbici direttamente ai centri cerebrali deputati alla regolazione emotiva, spiegando perché alterazioni intestinali si manifestino rapidamente come cambiamenti dell’umore.
La neuroinfiammazione rappresenta un terzo pathway fondamentale. I lipopolisaccaridi prodotti da batteri patogeni possono attraversare la barriera intestinale compromessa e attivare la microglia cerebrale, scatenando cascate infiammatorie che alterano la neurotrasmissione. La disbiosi potrebbe essere associata non solo a malattie gastroenterologiche ma anche a disturbi psichiatrici.
Gli acidi grassi a catena corta (SCFA) come butirrato, propionato e acetato rappresentano metaboliti chiave prodotti dalla fermentazione batterica. Questi composti attraversano la barriera emato-encefalica ed esercitano effetti neuroprotettivi diretti, riducendo la neuroinfiammazione e promuovendo la neuroplasticità attraverso meccanismi epigenetici che modificano l’espressione genica neuronale.
Psicobiotici: la nuova frontiera dei probiotici per la mente
I psicobiotici rappresentano una classe specializzata di probiotici specificamente selezionati per influenzare positivamente il sistema nervoso centrale attraverso l’asse intestino cervello. Uno studio sistematico del 2024 su 51 ricerche cliniche coinvolgenti 3353 pazienti ha mostrato un’efficacia notevolmente elevata nel trattamento specifico dei sintomi depressivi.
La combinazione più studiata clinicamente comprende Lactobacillus helveticus R0052 e Bifidobacterium longum R0175. Trial randomizzati controllati dimostrano che questa formulazione riduce significativamente i livelli di cortisolo salivare, migliora i punteggi di ansia e depressione, e aumenta la resilienza allo stress psicologico. I meccanismi d’azione includono la produzione di GABA e la modulazione dell’asse ipotalamo-ipofisi-surrene.

Negli ultimi cinque anni, alcuni ceppi psicobiotici hanno dimostrato di inibire l’infiammazione e diminuire i livelli di cortisolo, risultando in un miglioramento dei sintomi di ansia e depressione. Bifidobacterium breve CCFM1025 ha mostrato proprietà anti-ansia particolarmente pronunciate attraverso la produzione di acido γ-amminobutirrico.
La ricerca sui psicobiotici si sta orientando verso approcci personalizzati basati sul profiling microbico individuale. Le tecnologie di sequenziamento ad alta risoluzione permettono oggi di identificare disbiosi specifiche e formulare interventi mirati. Il meccanismo d’azione dei psicobiotici non è stato completamente investigato, tuttavia può conferire benefici modulando l’asse ipotalamo-ipofisi-surrene, influenzando direttamente la neuroinfiammazione.
I psicobiotici di nuova generazione includono formulazioni multi-ceppo progettate per targeting specifici: Lactobacillus rhamnosus per l’ansia, Bifidobacterium adolescentis per la depressione, e Akkermansia muciniphila per la neuroprotezzione. Questa precisione terapeutica rappresenta il futuro della neuropsichiatria basata sul microbioma, dove ogni paziente riceverà trattamenti ottimizzati per il proprio ecosistema microbico unico.
Evidenze cliniche sui disturbi mentali e microbioma
Le evidenze cliniche più recenti confermano in modo definitivo la connessione tra microbioma e depressione, ansia, disturbi cognitivi e condizioni neurodegenerative. Uno studio sistematico sui gemelli del registro TwinsUK ha identificato specifici squilibri microbici che sembrano influenzare lo stato di salute mentale, fornendo le prime evidenze geneticamente controllate dell’associazione microbiota-disturbi mentali.
Nel trattamento della depressione maggiore, studi clinici del 2024 hanno dimostrato che formulazioni psicobiotiche contenenti Lactobacillus acidophilus, Lactobacillus casei e Bifidobacterium bifidum riducono significativamente i punteggi della scala Hamilton per la depressione del 30-40% rispetto al placebo. Questi effetti sono accompagnati da riduzioni dei marcatori infiammatori sistemici e miglioramenti della qualità del sonno.
I disturbi d’ansia mostrano risposte particolarmente positive agli interventi psicobiotici. Una meta-analisi sistematica ha valutato l’effetto dei psicobiotici su ansia e stress in giovani di età 10-24 anni, dimostrando riduzioni significative dei sintomi ansiosi con effetti che persistono per almeno 8 settimane dopo l’interruzione del trattamento.

Nel corso dell’ultimo decennio, il coinvolgimento del microbiota intestinale nella comunicazione intestino-cervello è diventato focus di crescente interesse scientifico, stabilendo l’asse microbiota-intestino-cervello come campo di ricerca. Studi associativi esplorano il possibile ruolo del microbiota intestinale in memoria, apprendimento, ansia, stress, disturbi neurodeegenerativi e del neurosviluppo.
I disturbi dello spettro autistico rappresentano un’area di particolare interesse per gli interventi basati sul microbioma. Bambini con autismo mostrano frequentemente disbiosi intestinali caratterizzate da ridotta diversità microbica e predominanza di specie patobionte. Studi pilota con trapianti di microbiota fecale hanno mostrato miglioramenti comportamentali significativi, incluse ridotte stereotipie e migliorate competenze sociali, con effetti che persistono per oltre 2 anni.
Strategie terapeutiche personalizzate per il benessere mentale
La medicina personalizzata del microbioma rappresenta la frontiera più avanzata per ottimizzare la salute mentale attraverso interventi mirati sull’ecosistema intestinale. La ricerca su microbiota intestinale, nutrizione e salute mentale ha stabilito l’asse cervello-intestino-microbiota come regolatore chiave della neuroplasticità, aprendo possibilità terapeutiche precise e individualizzate.
L’approccio terapeutico integrato combina analisi del microbioma, valutazione nutrizionale, assessment psicologico e monitoraggio dei biomarcatori infiammatori per creare protocolli personalizzati. Il primo step prevede il sequenziamento metagenomico del microbioma fecale per identificare disbiosi specifiche, carenze di ceppi benefici e predominanza di specie patobionte.
La strategia nutrizionale personalizzata si basa sui risultati del profiling microbico. Pazienti con predominanza di Bacteroides beneficiano di diete ricche in fibre solubili e polifenoli, mentre quelli con carenza di Bifidobacterium necessitano di prebiotici specifici come inulina e frutto-oligosaccaridi. L’integrazione di alimenti fermentati viene calibrata sui ceppi mancanti identificati dall’analisi.
La supplementazione psicobiotica viene formulata su misura utilizzando ceppi specifici per i deficit individuali. Pazienti con ansia ricevono formulazioni ricche in Lactobacillus helveticus e Bifidobacterium longum, mentre quelli con depressione beneficiano di Lactobacillus plantarum e Bifidobacterium breve. Il dosaggio viene ottimizzato in base alla severità dei sintomi e alla risposta individuale.
Il monitoraggio longitudinale include valutazioni mensili del microbioma, biomarcatori infiammatori (IL-6, TNF-α, CRP), metaboliti microbici (SCFA) e assessment neuropsicologici standardizzati. Algoritmi di machine learning analizzano questi dati per predire risposte terapeutiche e aggiustare protocolli in tempo reale, massimizzando efficacia e minimizzando tempi di risposta.
Conclusione: Il futuro della neuropsichiatria basata sul microbioma
La rivoluzione del microbiota intestinale salute mentale sta trasformando la neuropsichiatria da disciplina farmaco-centrica a approccio olistico che considera l’essere umano come superorganismo complesso. Le evidenze scientifiche del 2024 dimostrano inequivocabilmente che il microbioma rappresenta un bersaglio terapeutico concreto per migliorare umore, cognizione e resilienza psicologica.
I cinque punti chiave emersi dalla ricerca più recente includono: primo, la comunicazione bidirezionale intestino-cervello avviene attraverso pathways neurali, immunitari e metabolici multipli; secondo, i psicobiotici offrono efficacia clinica comparabile ai farmaci tradizionali senza effetti collaterali; terzo, la personalizzazione terapeutica basata sul profiling microbico ottimizza risultati clinici; quarto, l’integrazione nutrizionale potenzia gli effetti psicobiotici; quinto, il monitoraggio longitudinale permette aggiustamenti terapeutici precissi.
Il prossimo passo è l’implementazione clinica su larga scala di protocolli personalizzati microbioma-based. La medicina del futuro integrerà sequenziamento microbico di routine, formulazioni psicobiotiche su misura e monitoraggio digitale continuo per creare ecosistemi terapeutici adattivi che evolvono con le esigenze individuali del paziente.
Inizia oggi il tuo percorso verso una migliore salute mentale: consulta un professionista specializzato in medicina del microbioma per una valutazione personalizzata del tuo ecosistema intestinale e scopri come ottimizzare naturalmente il tuo benessere neuropsichiatrico attraverso interventi scientificamente validati.
FAQ: Domande frequenti su microbiota e salute mentale
Quanto tempo servono i psicobiotici per fare effetto sulla salute mentale? Gli studi clinici mostrano miglioramenti iniziali dell’umore dopo 2-4 settimane di supplementazione costante con psicobiotici. Effetti ottimali si raggiungono generalmente dopo 8-12 settimane di trattamento continuo, con benefici che persistono per 4-8 settimane dopo l’interruzione.
I psicobiotici possono sostituire completamente i farmaci antidepressivi? I psicobiotici non devono mai sostituire terapie farmacologiche prescritte senza supervisione medica. Tuttavia, studi del 2024 dimostrano che possono essere utilizzati come terapia adiuvante per potenziare l’efficacia dei trattamenti tradizionali e ridurre dosaggi farmacologici.
Quali sono i migliori alimenti per supportare naturalmente il microbioma per la salute mentale? Alimenti fermentati come kefir, kimchi, miso e yogurt probiotico forniscono ceppi benefici. Fibre prebiotiche da legumi, avena, aglio e cipolle nutrono i batteri buoni. Pesce ricco di omega-3 riduce l’infiammazione intestinale supportando l’asse gut-brain.
Esistono test per analizzare il proprio microbioma intestinale? Sì, test metagenomici commerciali analizzano la composizione del microbioma fecale identificando ceppi presenti, diversità microbica e potenziali disbiosi. Tuttavia, l’interpretazione dei risultati richiede competenze specialistiche per formulare interventi terapeutici appropriati.
I bambini possono assumere psicobiotici per ansia e problemi comportamentali? Studi pediatrici del 2024 mostrano sicurezza ed efficacia dei psicobiotici in bambini sopra i 3 anni per ansia, ADHD e disturbi dello spettro autistico. Tuttavia, dosaggi e formulazioni devono essere specificamente calibrati per l’età e sempre sotto supervisione pediatrica specializzata.
Approfondimento: Guida pratica per ottimizzare il microbioma mentale
L’ottimizzazione pratica del microbioma per la salute mentale richiede un approccio sistematico che integri alimentazione strategica, stile di vita evidence-based e supplementazione mirata. La cronobiologia nutrizionale emerge come strategia innovativa: consumare la maggior parte delle calorie nelle prime 8 ore della giornata sincronizza i ritmi circadiani del microbioma, ottimizzando la produzione circadiana di metaboliti neuroattivi.
La dieta psicobiotica ideale include 30-40 grammi di fibre diverse giornalmente da almeno 20 fonti vegetali differenti per massimizzare la diversità microbica. Integra quotidianamente: 200ml di kefir o yogurt probiotico, 2-3 porzioni di verdure fermentate, 1 porzione di legumi, cereali integrali ricchi in beta-glucani, e 2-3 porzioni di pesce grasso settimanalmente per omega-3 anti-infiammatori.
L’esercizio fisico moderato (150 minuti settimanali) esercita effetti prebiotici diretti aumentando la produzione di SCFA e promuovendo Bifidobacterium. La meditazione mindfulness (10-20 minuti giornalieri) riduce il cortisolo e modula positivamente il microbioma attraverso la modulazione dell’asse stress. Il sonno di qualità (7-9 ore) mantiene i ritmi circadiani microbici essenziali per l’equilibrio neurochimico.
Evita antibiotici non necessari, alcol eccessivo, zuccheri raffinati e additivi alimentari che danneggiano la diversità microbica. Implementa gradualmente questi cambiamenti nell’arco di 4-6 settimane per permettere l’adattamento del microbioma e monitora miglioramenti dell’umore, energia e qualità del sonno come indicatori di progresso verso l’ottimizzazione del tuo ecosistema mentale.
“Leggi anche: Digiuno a 8 Ore Perdita di Peso Sostenuta: 7 Strategie Efficaci”